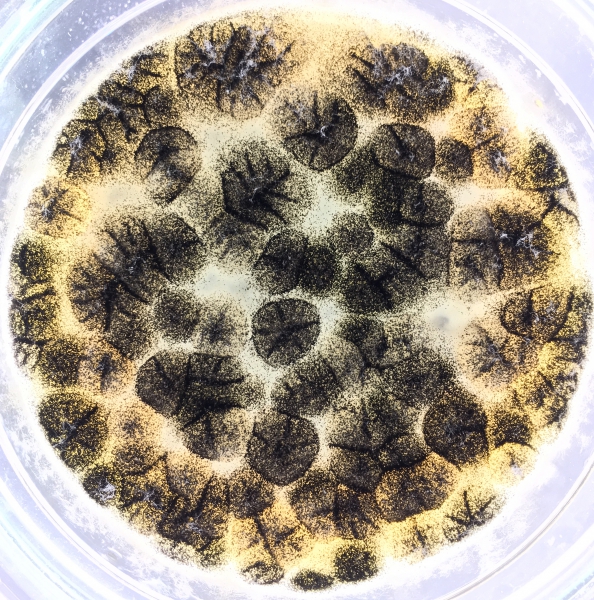

Test skuteczności i ocena zakonserwowania produktów kosmetycznych
Autor: Damian Sztucki
Istnieje kilka różnych środków ochronnych stosowanych przeciwko rozwojowi drobnoustrojów w produktach kosmetycznych, które można podzielić na cztery grupy: chemiczne środki konserwujące, składniki preparatu będące jednocześnie konserwantami, rodzaj użytego opakowania oraz proces tworzenia i obróbki kosmetyku. Wykonując badania obciążeniowe (ang. challenge test) produktów kosmetycznych możliwa jest ocena skuteczności zakonserwowania danego wyrobu i analiza ryzyka związanego z ewentualnym rozwojem mikroflory patogennej. Test ten, zwany testem konserwacji, wykonywany jest zgodnie z międzynarodową normą PN-EN ISO 11930:2012 i nie jest wymagany w przypadku produktów o niskim ryzyku zakażeń mikrobiologicznych. Oprócz sprawdzenia stabilności użytego środka konserwującego w okresie ważności produktu kosmetycznego, testy konserwacji mogą być także wykorzystywane przy doborze odpowiedniego środka lub do wyznaczania okresu przydatności po otwarciu, tzw. PAO (ang. Period After Open). Aby upewnić się, że dany produkt kosmetyczny posiada stabilny układ konserwujący zaleca się przeprowadzanie badań obciążeniowych zarówno na etapie opracowywania receptury, jak i na produkcie końcowym w opakowaniu handlowym.
Ogólne wytyczne i przebieg badania obciążeniowego
Test obciążeniowy został zaprojektowany głównie z myślą o produktach stanowiących wysokie ryzyko mikrobiologiczne, czyli między innymi kosmetykach opartych w swoim składzie na wodzie. Badanie zakłada użycie pięciu patogennych mikroorganizmów (trzech bakterii, grzyba drożdżopodobnego oraz grzyba pleśniowego) w odpowiednim stężeniu i objętości, zaaplikowanych do produktu kosmetycznego umieszczonego na czas trwania badania w opakowaniu zastępczym i mierzeniu zmian w liczebności otrzymywanych drobnoustrojów w ustalonych odstępach czasowych. Aby dopuścić produkt do testu konserwacji należy uprzednio potwierdzić jego jałowość wykonując standardowe badanie czystości mikrobiologicznej w oparciu o odpowiednie normy ISO.
Pierwszy etap ewaluacji zakonserwowania produktu kosmetycznego (czas T0) opiera się na kontrolowanym, jednorazowym wprowadzeniu referencyjnych szczepów mikroorganizmów, co ma odzwierciedlać sytuację wtórnego zakażenia (kontaminacji) kosmetyku, jakie może powstać podczas użytkowania wyrobu przez konsumenta [Tab.1]. Drobnoustroje użyte w badaniu stanowią najczęstsze zanieczyszczenie kosmetyków, równocześnie będąc powszechnymi patogenami człowieka. Są to mikroorganizmy, których obecność (za wyjątkiem Aspergillus brasiliensis nieobjętego obowiązkiem wykrywania) jest niedopuszczalna w przypadku badania czystości mikrobiologicznej produktów kosmetycznych.
Tabela 1. Wykaz szczepów referencyjnych używanych w teście obciążeniowym
|
Szczep testowy |
Numer referencyjny |
|
Escherichia coli |
ATCC 8739 |
|
Staphylococcus aureus |
ATCC 6538 |
|
Pseudomonas aeruginosa |
ATCC 9027 |
|
Candida albicans |
ATCC 10231 |
|
Aspergillus brasiliensis |
ATCC 16404 |
Szczepy bakteryjne wyhodowane na podłożu TSA (ang. Tryptic Soy Agar) oraz grzyby poddane hodowli na podłożu SDA (ang. Sabouraud Dextrose Agar dla C.albicans) i PDA (ang. Potato Dextrose Agar dla A.brasiliensis) są testowane osobno i wprowadzane do kosmetyku po wcześniejszym ustaleniu ich gęstości optycznej i co najważniejsze stężenia, które dla bakterii powinno mieścić się w zakresie 1×107-1×108 cfu/ml i 1×106-1×107 cfu/ml dla grzybów. Liczba ta stanowi w tym teście wartość N, którą należy potwierdzić wykonując szereg rozcieńczeń dziesięciokrotnych tej zawiesiny i ich posiewie na podłożach TSA, SDA i PDA.
Zawiesiny wszystkich szczepów bakteryjnych oraz Candida albicans przygotowywane są w identyczny sposób, poprzez zawieszanie komórek szczepów w rozcieńczalniku, a następnie ustaleniu ilość cfu/ml. W przypadku grzyba pleśniowego Aspergillus brasiliensis należy wziąć pod uwagę fakt, że jest to grzyb produkujący spory, wyrastające i górujące nad koloniami na szalce Petriego (Rys.1). W tym przypadku zawiesinę otrzymuje się poprzez zalanie płytki z inkubowanym grzybem 10 ml polysorbatu i delikatne wytrząsanie płytki, tak aby spory uwolniły się z grzybni i znalazły się w płynie. Taki płyn należy poddać filtracji oraz ponownym zawieszeniom i rozcieńczeniom, jeśli istnieje taka potrzeba, a następnie ustalić ilość spor w zawiesinie, aby odpowiadały wspomnianemu zakresowi cfu/ml. Wszystkie gotowe zawiesiny powinny być użyte tego samego dnia, najlepiej w czasie dwóch godzin od ich przygotowania.
Rys. 1. Wzrost grzyba pleśniowego Aspergillus brasiliensis na podłożu hodowlanym PDA.
Kolejnym etapem analizy konserwacji produktów kosmetycznych jest naważenie 20 g lub odmierzenie 20 ml badanego wyrobu do sterylnego opakowania (np. plastikowe) w pięciu powtórzeniach, przypadających po jednym na każdy używany szczep. Następnie do każdego opakowania należy dodać 0,2 ml odpowiedniej zawiesiny drobnoustrojów. W ten sposób można uzyskać końcowe ich stężenie (wartość N0) 1×105-1×106 cfu/ml dla bakterii oraz 1×104-1×105 cfu/ml dla grzybów, poprzez stukrotne rozcieńczenie w kosmetyku. Taki produkt trzeba dokładnie wymieszać, w celu rozprowadzenia inokulum w całej jego objętości i poddać inkubacji w temperaturze 22,5±2,5oC przez okres 28 dni, w ciągu których będzie poddawany ocenie mikrobiologicznej po 7, 14 i 28 dniach od momentu zaszczepienia.
Tabela 2. Wykaz szczepów badanych w odpowiednich interwałach czasowych wyrażonych w dniach
od momentu zaszczepienia produktu kosmetycznego
|
|
Czas badania produktu |
||
|
Szczep testowy |
T7 |
T14 |
T28 |
|
Escherichia coli |
+ |
+ |
+ |
|
Staphylococcus aureus |
+ |
+ |
+ |
|
Pseudomonas aeruginosa |
+ |
+ |
+ |
|
Candida albicans |
+ |
+ |
+ |
|
Aspergillus brasiliensis |
– |
+ |
+ |
Sprawdzenie wydajności neutralizatora
Neutralizator powinien mieć dwie podstawowe właściwości: zdolność zneutralizowania działania konserwantu zawartego w formule kosmetyku oraz brak hamującego wpływu na bakterie i grzyby. Test jego wydajności można przeprowadzić w momencie rozpoczęcia każdego badania obciążeniowego (T0), albo potwierdzić jego skuteczność wraz z jego każdym nowym przygotowaniem, bądź nowym opakowaniem. W skrócie, jego wykonanie opiera się na dostarczeniu skalibrowanej ilości mikroorganizmów (każdego szczepu, około 103 cfu/ml) do probówki z neutralizatorem zawierającym 1g badanego produktu kosmetycznego (probówka testowa) oraz do drugiej probówki, w której znajduje się sam neutralizator (probówka kontrolna).
Probówki testowe należy, tak jak w przypadku normalnego badania obciążeniowego, odstawić na około 30 min w temperaturze pokojowej, aby dać czas na zadziałanie neutralizatora. W międzyczasie przygotować należy próby kontrolne, w którym zamiast produktu kosmetycznego, do neutralizatora dodać należy 1 ml rozcieńczalnika używanego do szeregu rozcieńczeń każdej próby w teście konserwacji. W ten sposób w obu przypadkach (test i kontrola) końcowa objętość będzie wynosiła 11 ml (9 ml neutralizatora +1 ml produktu/rozcieńczalnika +1ml zawiesiny szczepu). Po tym czasie próby testowe trzeba zaszczepić 1ml zawiesiny mikroorganizmów i w co najmniej dwóch powtórzeniach wykonać posiew wgłębny na odpowiednie podłoże hodowlane. Do probówek kontrolnych należy jedynie dodać po 1 ml danej zawiesiny mikroorganizmu i następnie po dokładnym wymieszaniu wykonać posiew na odpowiednie podłoże hodowlane.
Przy ocenie efektywności działania neutralizatora wziąć należy pod uwagę dwa aspekty. Pierwszy z nich to porównywalna ilość kolonii uzyskanych na płytkach w przypadku próby kontrolnej oraz w przypadku posiewu czystej zawiesiny. W ten sposób dowieść można o nietoksycznym działaniu neutralizatora na szczep testowy. Drugim aspektem jest przypadek, kiedy liczba kolonii uzyskanych w próbie testowej (neutralizator + produkt) musi wynosić co najmniej połowę liczby kolonii uzyskanych w próbie kontrolnej (neutralizator + szczep). W ten sposób można przekonać się o wydajności neutralizatora, który zadziałał na środek konserwujący w produkcie kosmetycznym nie powodując zahamowania możliwości wzrostu drobnoustrojów.
Jeśli zdarzy się, że wyniki nie spełniają tych wymagań, możliwa jest modyfikacja używanego neutralizatora, bądź jego zmiana na inny.
Badanie obciążeniowe po 7, 14 i 28 dniach
Wtórnie zakażony produkt poddany inkubacji w określonych warunkach należy sprawdzać pod kątem rozwoju, bądź braku rozwoju zaaplikowanych w nim drobnoustrojów w ściśle określonych odstępach czasowych: po 7, 14 i 28 dniach. Test ten polega na pobraniu 1 g lub 1 ml takiego kosmetyku z opakowania, w którym jest inkubowany i dodania do 9 ml przygotowanego neutralizatora (np. Eugon LT-100). Jego rolą jest neutralizacja działania konserwantu zawartego w produkcie kosmetycznym z jednoczesnym brakiem hamującego wpływu na rozwój mikroorganizmów, a więc będzie się przyczyniał do swobodnego namnażania zawartych drobnoustrojów, zakładając, że takowe przeżyły w danej formule konserwującej. W takiej postaci należy pozostawić kosmetyk w neutralizatorze przez 30±15 minut w temperaturze pokojowej.
W przypadku pierwszego badania od czasu zaszczepienia kosmetyku, czyli po siedmiu dniach (T7), nie jesteśmy w stanie przewidzieć efektywności układu konserwującego. Z tego powodu zaleca się wykonanie szeregu rozcieńczeń badanego w tym momencie produktu, najlepiej do rozcieńczenia 106, w celu możliwego i pewnego zliczenia kolonii drobnoustrojów. Po wykonaniu szeregu rozcieńczeń formulacji dla każdego szczepu, należy przenieść po 1ml danego rozcieńczenia na szalkę Petriego i zalać około 20 ml odpowiedniego podłoża hodowlanego: TSA dla bakterii, SDA dla C.albicans i PDA dla A.brasiliensis. Zestalone płytki trzeba poddać inkubacji w 32,5±2,5oC przez 48-72 h dla bakterii oraz C.albicans, natomiast w 22,5±2,5oC przez 3-5 dni dla A.brasiliensis.
Po zakończonym okresie inkubacji wszystkie otrzymane kolonie z wszystkich rozcieńczeń należy policzyć, uwzględniając przy tym istotność wyników dla wszystkich mikroorganizmów w zakresie 30-300 kolonii, z wyjątkiem A.brasiliensis, dla którego zakres ten wynosi 15-150 kolonii. Jeśli liczba żywych drobnoustrojów zawiera się poza limitem, czyli wynosi więcej niż 300 (150 dla A.brasiliensis) bądź mniej niż 30 (15 dla A.brasiliensis), wynik taki należy podać jako wartość >300 (>150 dla A.brasiliensis)lub <30 (<15 dla A.brasiliensis).

Rys.2. Skrócony schemat wykonania testu konserwacji dla produktów kosmetycznych.
T – interwały czasowe wyrażone w dniach od zaszczepienia produktu;
* – w czasie T7 ocenie mikrobiologicznej nie jest poddawana próba zaszczepiona szczepem
Aspergillus brasiliensis, jego pierwsza ocena następuje w 14-tej dobie (T14).
Liczenie żywych mikroorganizmów
Liczbę drobnoustrojów obecnych w zawiesinie wyjściowej (N) można obliczyć za pomocą wzoru:
N = C/(V x d),
gdzie C oznacza liczbę kolonii obecnych na płytce, V to objętość zaaplikowanego inokulum na płytkę wyrażona w ml, natomiast d to rozcieńczenie, z którego liczba kolonii została policzona. Liczba taka, jak zostało już wspomniane wcześniej powinna oscylować w zakresie zakresie 1×107-1×108 cfu/ml i 1×106-1×107 cfu/ml dla grzybów. Liczba mikroorganizmów obecna w czasie T0 obecna w kosmetyku będzie wynosiła N0=N/100, ponieważ zostało dostarczone 0,2 ml zawiesiny do 20g produktu, co stanowi jej stukrotne rozcieńczenie. W tym przypadku N0 powinno wynosić 1×105-1×106 cfu/ml dla bakterii oraz 1×104-1×105 cfu/ml dla grzybów.
Analogicznie do wzoru użytego przy liczeniu liczby żywych organizmów obecnych w zawiesinie wyjściowej, w identyczny sposób należy wyliczyć liczbę tych drobnoustrojów w czasie Nx, czyli N7, N14 i N28. W ten sposób będzie można oznaczyć wartość redukcji wyrażoną w jednostkach logarytmicznych, za pomocą wzoru Rx = lgN0 – lgNx. Najczęściej wskaźnik redukcji będzie wyraźny wraz z wydłużającym się czasem inkubacji zakażonego produktu. Może się jednak okazać, że redukcja drobnoustrojów nie zostanie zauważona, co będzie wskazywało na brak hamującego działania układu konserwującego, jednakże będzie on hamował dalsze namnażanie mikroorganizmów. Trzecim możliwym scenariuszem jest wzrost liczby bakterii i grzybów, co spowodowane będzie nieefektywnym działaniem konserwantu, lub zbyt niskiego jego stężenia użytego w przygotowanym wyrobie kosmetycznym. W takim przypadku, po zmianie receptury badanie obciążeniowe należy powtórzyć, aby mieć pewność co do efektywności wyższego stężenia danego konserwantu, lub wykorzystać inny środek konserwujący.
Jeśli uzyskane po 7 dniach wyniki wskazują na brak wzrostu bakterii i grzybów, lub na ich obecność jedynie w niskich rozcieńczeniach, np. 102, można zredukować liczbę rozcieńczeń w badaniu po 14 i 28 dniach, ponieważ spodziewać się można dalszej redukcji, bądź dalszego braku wzrostu. Wyjątkiem w tym przypadku może być testowanie rozwoju grzyba pleśniowego Aspergillus brasiliensis, ponieważ jest on badany po raz pierwszy właśnie po 14 dniach (T14), dlatego dla niego sugerowane jest przygotowanie dla pewności pełnego zestawu szeregu rozcieńczeń.
Tabela 3. Kryteria ewaluacji przeprowadzonego testu obciążeniowego. 1) NI – brak wzrostu w porównaniu z poprzednim czasem badania. 2) Rx=0 kiedy lgN0=lgNx, czyli nie nastąpiła zmiana w liczbie w porównaniu do czasu początkowego
|
|
Wartości redukcji wyrażone w jednostkach logarytmicznych |
|||||||
|
Mikroorganizm |
|
Bakterie |
|
|
C. albicans |
A. brasiliensis |
||
|
Czas badania |
T7 |
T14 |
T28 |
T7 |
T14 |
T28 |
T14 |
T28 |
|
Kryterium A |
≥3 |
≥3 lub NI1 |
≥3 lub NI |
≥1 |
≥1 lub NI |
≥1 lub NI |
≥02 |
≥1 |
|
Kryterium B |
Nie wykonano |
≥3 |
≥3 lub NI |
Nie wykonano |
≥1 |
≥1 lub NI |
≥0 |
≥ lub NI |
Interpretacja uzyskanych wyników
Dane przedstawione za pomocą wartości redukcji wyrażonej w jednostkach logarytmicznych są przyrównywane do minimalnych wartości niezbędnych do spełnienia jednego z dwóch kryteriów: A lub B. Oba kryteria reprezentują ochronną zdolność produktów kosmetycznych. Kryterium A zostaje spełnione, kiedy produkt jest chroniony przed namnażaniem się mikroorganizmów, czyli nie stanowi on potencjalnego ryzyka dla jego użytkownika. Natomiast kryterium B świadczy o poziomie ryzyka, który jest akceptowalny, jeśli jego analiza wykazała istnienie innych, niezwiązanych z samym wyrobem, czynników wykazujących właściwości ograniczające rozwój drobnoustrojów tolerowane w produktach kosmetycznych.
Dla każdego z testowanych szczepów należy porównać wartości Rx z kryteriami A i B. Jeśli wartości redukcji mieszczą się w zakresie kryterium A, to produkt taki pozytywnie przechodzi badanie obciążeniowe, spełniając jednocześnie warunki wykazane w normie ISO. Podobnie jest w przypadku, kiedy wartości redukcji mieszczą się w kryterium B. Produkt taki pozytywnie przechodzi test konserwacji, jednakże dodatkowe czynniki i ich uzasadnienie powinno zostać przedstawione w celu spełnienia wymagać prezentowanych w normie ISO. Analogicznie do tych sytuacji, jeśli chociaż jedna z wartości nie spełnia kryterium A lub B, wynik testu konserwacji tego wyrobu jest negatywny.
Ocena zakonserwowania produktów kosmetycznych
Na ochronę przeciwko rozwojowi mikroflory bakteryjnej i grzybiczej w produkcie kosmetycznym wpływają: skład formuły, warunki produkcji oraz opakowanie, w jakim się znajduje. W celu określenia wydajności zastosowanych środków ochronnych przeprowadza się standardowy test konserwacji. Uzyskane wyniki ze wszystkich odstępów czasowych (T7, T14, T28) muszą spełnić jedno z dwóch kryteriów dopuszczalnych przez Międzynarodowy Standard ISO 11930. Jeżeli produkt nie spełnia wymaganych kryteriów, należy określić jego poziom ryzyka mikrobiologicznego, ponieważ pomimo braku spełnienia warunków przez formułę wyrobu, jego przeznaczenie, bądź ograniczona objętość mogą zostać uznane za poziom tolerowanego ryzyka. Przykładem takich produktów są jednorazowego użytku próbki kosmetyków w plastikowych opakowaniach, albo powszechnie nazywane produkty o niskim ryzyku mikrobiologicznym.
Na podstawie i po zakończeniu przeprowadzonego badania wykonuje się raport z testu skuteczności o oceny zakonserwowania produktu kosmetycznego, opisujący ze szczegółami wszystkie dane dotyczące badanego kosmetyku. W jego zawartości musi znajdować się odniesienie do normy ISO 11930, dane laboratorium przeprowadzającego badanie, charakterystyka testowanego produktu kosmetycznego, zakres i opis wykonywanych analiz, metodyka (procedura przechowywania próbek, oraz metodyka badawcza), wyniki badania oraz wnioski wyciągnięte na podstawie uzyskanych rezultatów. W ten sposób powstaje dokument zapewniający o braku możliwości rozwoju w nim bakterii i grzybów zwłaszcza patogennych dla człowieka (pomijając inne czynniki mogące wpłynąć na możliwość kontaminacji produktu, takie jak np. ilość użytkowników danego wyrobu, lub poziom higieny), ale przede wszystkim o efektywności zastosowanych przez producenta środków ochronnych w jego produkcie kosmetycznym.
Bibliografia
- PN-EN ISO 21148:2017-07 Kosmetyki. Mikrobiologia. Ogólne wytyczne badań mikrobiologicznych.
- PN-EN ISO 11930:2012/Ap1:2017-05 Kosmetyki. Mikrobiologia. Test skuteczności I ocean zakonserwowania produktów kosmetycznych.
- Chusteczki nawilżane z mikrobiologicznego punktu widzenia – nowa metoda badań obciążeniowych. Chemia i Biznes, Rynek kosmetyczny i chemii gospodarczej 3/2015.
